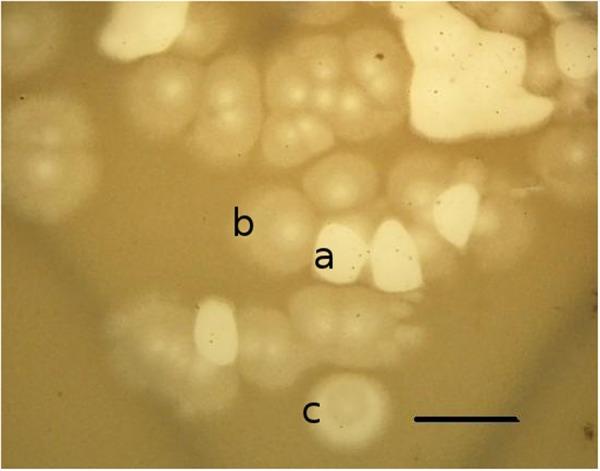
https://cdn.ncbi.nlm.nih.gov/pmc/blobs/78b0/5062033/f18c772c9a00/fmicb-07-01631-g008.jpg
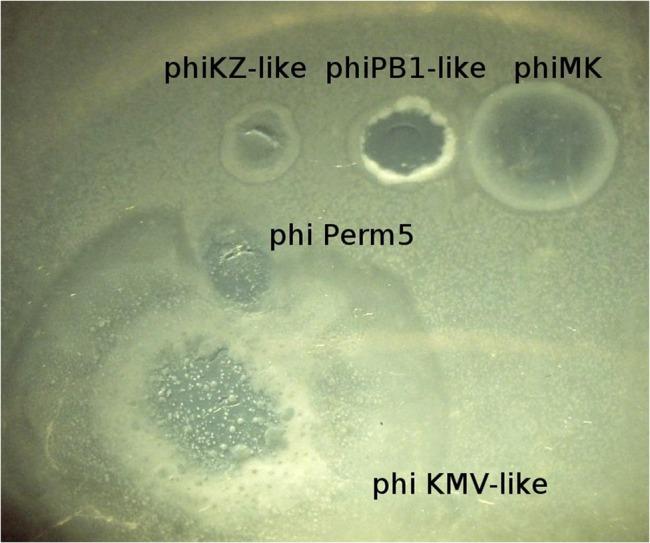
https://cdn.ncbi.nlm.nih.gov/pmc/blobs/78b0/5062033/7f524f0c981e/fmicb-07-01631-g002.jpg
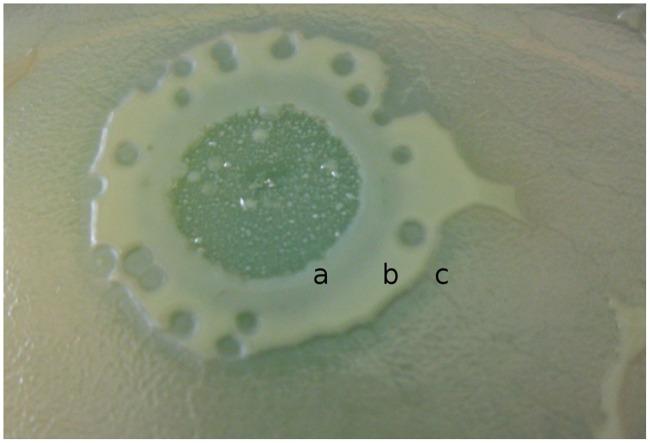
https://cdn.ncbi.nlm.nih.gov/pmc/blobs/78b0/5062033/dee059150792/fmicb-07-01631-g005.jpg
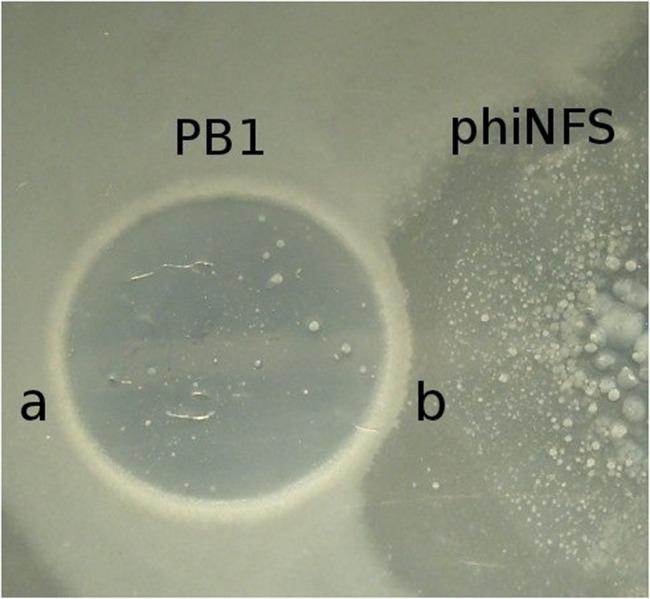
https://cdn.ncbi.nlm.nih.gov/pmc/blobs/78b0/5062033/6634234dabcf/fmicb-07-01631-g007.jpg

用于选择靶向噬菌体的模块化方法及其在患有囊性纤维化儿童中的应用
Modular Approach to Select Bacteriophages Targeting for Their Application to Children Suffering With Cystic Fibrosis.
作者信息
Krylov Victor, Shaburova Olga, Pleteneva Elena, Bourkaltseva Maria, Krylov Sergey, Kaplan Alla, Chesnokova Elena, Kulakov Leonid, Magill Damian, Polygach Olga
机构信息
Laboratory for Genetics of Bacteriophages, Department of Microbiology, I.I. Mechnikov Research Institute for Vaccines and Sera Moscow, Russia.
Medical Biology Centre, School of Biological Sciences, Queen's University Belfast Belfast, UK.
出版信息
Front Microbiol. 2016 Oct 13;7:1631. doi: 10.3389/fmicb.2016.01631. eCollection 2016.
This review discusses the potential application of bacterial viruses (phage therapy) toward the eradication of antibiotic resistant in children with cystic fibrosis (CF). In this regard, several potential relationships between bacteria and their bacteriophages are considered. The most important aspect that must be addressed with respect to phage therapy of bacterial infections in the lungs of CF patients is in ensuring the continuity of treatment in light of the continual occurrence of resistant bacteria. This depends on the ability to rapidly select phages exhibiting an enhanced spectrum of lytic activity among several well-studied phage groups of proven safety. We propose a modular based approach, utilizing both mono-species and hetero-species phage mixtures. With an approach involving the visual recognition of characteristics exhibited by phages of well-studied phage groups on lawns of the standard PAO1 strain, the simple and rapid enhancement of the lytic spectrum of cocktails is permitted, allowing the development of tailored preparations for patients capable of circumventing problems associated with phage resistant bacterial mutants.
本综述探讨了细菌病毒(噬菌体疗法)在根除囊性纤维化(CF)儿童抗生素耐药性方面的潜在应用。在这方面,考虑了细菌与其噬菌体之间的几种潜在关系。对于CF患者肺部细菌感染的噬菌体疗法,必须解决的最重要方面是鉴于耐药细菌的持续出现,确保治疗的连续性。这取决于能否在几个经过充分研究且已证明安全的噬菌体组中快速筛选出具有增强裂解活性谱的噬菌体。我们提出一种基于模块的方法,利用单物种和异物种噬菌体混合物。通过一种涉及在标准PAO1菌株菌苔上视觉识别经过充分研究的噬菌体组所表现出的特征的方法,可以简单快速地增强鸡尾酒噬菌体的裂解谱,从而开发出能够规避与噬菌体耐药细菌突变体相关问题的针对患者的定制制剂。